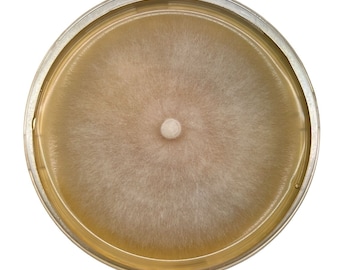
Colonised Mushroom Mycelium Agar Plates /petri dish (Allow 2-4 weeks)

Rootlabau Privacy Policy
Last updated 24 April 2023.
This Privacy Policy describes how and when Rootlabau (“us”, “our”, “we”) collects, uses, and shares information when you purchase an item from Rootlabau (https://www.etsy.com/au/shop/RootLabAU), contact us, or otherwise use our services through Etsy.com or its related sites and services.
You agree that by purchasing an item from Rootlabau or otherwise interacting with Rootlabau, you have read, understood, and agree to be bound by all of the terms of this Privacy Policy. If you disagree, you must leave Rootlabau immediately.
We may change this Privacy Policy from time to time. If we make changes, we will notify you by revising the date at the top of the page.
This Privacy Policy does not apply to the practices of third parties that we do not own or control, including Etsy or any third party services you access through Etsy or through Rootlabau. You can reference the Etsy Privacy Policy to learn more about Etsy’s privacy practices.
Additionally, we will make every reasonable effort to inform you when we interact with third parties with your information; however, you are solely responsible for reviewing, understanding, and agreeing to or not agreeing to any third-party privacy policies.
Information we Collect
To fulfill your order, you must provide us with certain information (which you authorized Etsy to provide to us), such as your name, e-mail address, postal address, payment information, and the details of the product that you’re ordering. You may also choose to provide us with additional personal information from time to time if you contact us directly.
Why we Need Your Information and How we Use It
We collect, use and share your information in several legally-permissible ways, including:
- As needed to provide our services, such as when we use your information to fulfill your order, to settle disputes, or to provide you with customer support;
- When you have provided your affirmative consent, which you may revoke at any time, such as by signing up for our mailing list or to receive notifications from us;
- If necessary to comply with a court order or legal obligation, such as retaining information about your purchases if required by tax law; and
- As necessary for our own legitimate interests, if those legitimate interests are not overridden by your rights or interests, such as (a) providing and enhancing our services; (b) Compliance with the Etsy Seller Policy and Etsy Terms of Use; and (c) use of your e-mail address for remarketing on Facebook, Google or similar.
Information Sharing and Disclosure
Protecting our customers’ personal information is crucial to our business and something we take very seriously. For these reasons, we share your personal information only for very limited reasons and in limited circumstances, as follows:
- With Etsy. we share your information with Etsy as necessary to provide you our services and comply with my obligations under both the Etsy Seller Policy and Etsy Terms of Use;
- With Third-Party Service Providers. we engage the following trusted third parties to perform functions and provide services to our shop:
Google Analytics, which helps us understand how visitors browse Rootlabau. You can read more about how Google uses your Personal Information here: https://www.google.com/intl/en/policies/privacy/. You can also opt out of Google Analytics here: https://tools.google.com/dlpage/gaoptout.
Multiorder, Managing product inventory and orders
Australia Post and other logistic providers to ship your order
We share your personal information with these third parties, but only to the extent necessary to perform these services;
- In the event of a Business Transfer. If we sell or merge our business, we may disclose your information as part of that transaction only to the extent permitted by law.
- In Compliance with Laws. we may collect, use, retain, and share your information if we have a good faith belief that doing so is reasonably necessary to: (a) respond to legal process or to government requests; (b) perform legal obligations to which we are bound by agreements; (c) prevent, investigate, and address fraud and other illegal activity, security, or technical issues; or (d) protect the rights, property, and safety of my customers, or others.
How Long we Store Your Information
We retain your personal information only for as long as necessary to provide you with our services and as otherwise described in our Privacy Policy. However, we may also be required to retain this information to comply with my legal and regulatory obligations, to resolve disputes, and to enforce or perform under our agreements. we generally keep your data for the following period: seven (7) years.
Transfers of Personal Information Outside the EU
We may store and process your information through third-party hosting services in the US and other jurisdictions. As a result, we may transfer your personal information to a jurisdiction with different data protection and government surveillance laws than your jurisdiction has. If we are required to transfer information about you outside of the EU, we rely on Privacy Shield as the legal basis for the transfer, as Google Cloud is Privacy Shield certified.
Your Rights
If you reside in certain territories, including the EU, you have a number of rights in relation to your personal information. While some of these rights apply generally, certain rights apply only in certain limited cases. Your rights are as follows:
- Right to Access. You may have the right to access and receive a copy of the personal information we hold about you by contacting us using the contact information below.
- Right to Change, Restrict, or Delete. You may also have rights to change, restrict our use of, or delete your personal information. Absent exceptional circumstances (such as where we are required to store information for legal reasons) We will generally delete your personal information upon your request.
- Right to Object. You can object to (a) our processing of some of your information based on my legitimate interests and (b) receiving marketing messages from us. In such cases, we will delete your personal information unless we have compelling and legitimate grounds to continue storing and using your information or if it is needed for legal reasons.
- Right to Complain. If you reside in the EU and wish to raise a concern about our use of your information (and without prejudice to any other rights you may have), you have the right to do so with your local data protection authority.
How to Contact us
You may reach me with any concerns relating to privacy at info@rootlab.com.au , or by mail at our postal address PO BOX 3004 Marrickville Metro, NSW 2204, addressed to Rootlab.